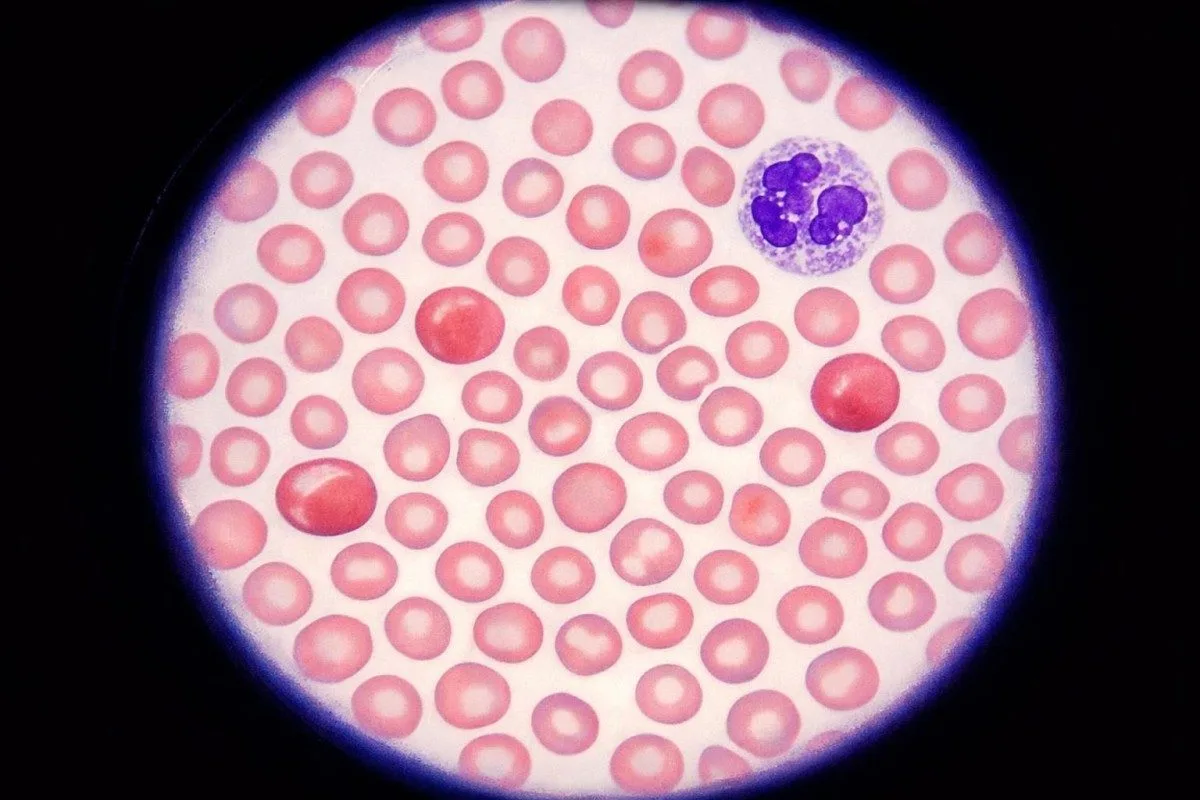
ανασκόπηση αναφοράς εξετάσεων αίματος με κλινική εποπτεία και υποστήριξη ερμηνείας με AI

Η τιμολόγηση εργαστηριακών εξετάσεων με πληρωμή από την τσέπη (cash-pay) έχει περισσότερο νόημα όταν διαχωρίσετε την τιμή της εξέτασης από το κόστος της επίσκεψης, το κόστος λήψης δείγματος και το επακόλουθο “cascade” παρακολούθησης. Ιδού τι πληρώνουν ρεαλιστικά οι ασθενείς στις Η.Π.Α. το 2026—και πού κρύβονται οι ακριβές εκπλήξεις.
Αυτός ο οδηγός γράφτηκε υπό την ηγεσία του Δρ. Τόμας Κλάιν, MD σε συνεργασία με το Ιατρική Συμβουλευτική Επιτροπή Kantesti AI, συμπεριλαμβανομένων των συνεισφορών του καθηγητή Δρ. Hans Weber και της ιατρικής ανασκόπησης της Δρ. Sarah Mitchell, MD, PhD.

Τόμας Κλάιν, MD
Κύριος Ιατρός, Kantesti AI
Ο Δρ. Thomas Klein είναι πιστοποιημένος κλινικός αιματολόγος και παθολόγος με πάνω από 15 χρόνια εμπειρίας στην εργαστηριακή ιατρική και στην κλινική ανάλυση με υποβοήθηση AI. Ως Chief Medical Officer στην Kantesti AI, ηγείται των διαδικασιών κλινικής επικύρωσης και επιβλέπει την ιατρική ακρίβεια του νευρωνικού δικτύου μας 2.78 τρισεκατομμυρίων παραμέτρων. Ο Δρ. Klein έχει δημοσιεύσει εκτενώς σχετικά με την ερμηνεία βιοδεικτών και τις εργαστηριακές διαγνώσεις σε αξιολογημένα ιατρικά περιοδικά.

Σάρα Μίτσελ, MD, PhD
Κύριος Ιατρικός Σύμβουλος - Κλινική Παθολογία & Εσωτερική Παθολογία
Η Δρ. Sarah Mitchell είναι πιστοποιημένη κλινική παθολόγος με πάνω από 18 χρόνια εμπειρίας στην εργαστηριακή ιατρική και στην διαγνωστική ανάλυση. Διαθέτει εξειδικευμένες πιστοποιήσεις στην κλινική χημεία και έχει δημοσιεύσει εκτενώς σχετικά με πάνελ βιοδεικτών και εργαστηριακή ανάλυση στην κλινική πρακτική.

Καθηγητής Δρ. Χανς Βέμπερ, PhD
Καθηγητής Εργαστηριακής Ιατρικής & Κλινικής Βιοχημείας
Ο Καθ. Δρ. Hans Weber διαθέτει 30+ χρόνια εμπειρίας στην κλινική βιοχημεία, την εργαστηριακή ιατρική και την έρευνα βιοδεικτών. Πρώην Πρόεδρος της Γερμανικής Εταιρείας Κλινικής Χημείας, ειδικεύεται στην ανάλυση διαγνωστικών πάνελ, στην τυποποίηση βιοδεικτών και στην εργαστηριακή ιατρική με υποβοήθηση AI.
- ΚΤΚ cash-pay συνήθως κοστίζει $10-$35 σε εργαστήρια άμεσης πρόσβασης.
- CMP συχνά κοστίζει $10-$40; επιλέξτε BMP αντί για αυτό αν χρειάζεστε μόνο ηλεκτρολύτες και νεφρική λειτουργία.
- Λιπιδικό πάνελ η τιμολόγηση συνήθως είναι $15-$50, καθιστώντας την μία από τις υψηλότερης απόδοσης εξετάσεις προσυμπτωματικού ελέγχου κάτω από $50.
- HbA1c συνήθως κοστίζει $15-$45 και δεν δεν απαιτεί νηστεία.
- TSH συνήθως κοστίζει $20-$70; αντανακλαστικό ελεύθερη T4 μπορεί να προσθέσει άλλο ένα $15-$50.
- Βιταμίνη D είναι από τα πιο ακριβά συνήθη πρόσθετα, περίπου $45-$110 πληρωμή μετρητοίς.
- επείγουσα φροντίδα συχνά γίνεται ακριβή επειδή μόνο το κόστος της επίσκεψης συνήθως είναι $99-$250 πριν από τις χρεώσεις για το εργαστήριο.
- κιτ στο σπίτι συχνά είναι 1,3x έως 2,5x πιο ακριβά ανά αναλύτη από μια απευθείας λήψη από εργαστήριο.
- χρεώσεις λήψης συνήθως προσθέτουν $5-$25, και οι χρεώσεις για τη διαχείριση του δείγματος ή για συλλογή στο ιατρείο μπορούν να προσθέσουν άλλο ένα $3-$35.
Πόσο κοστίζει συνήθως μια απλή εξέταση αίματος χωρίς ασφάλιση
Οι περισσότερες συνήθεις εξετάσεις αίματος με πληρωμή μετρητοίς κοστίζουν $8-$55 η καθεμία σε αμερικανικά εργαστήρια απευθείας πρόσβασης, ενώ τα συνήθη πακέτα με συνδυασμένες εξετάσεις συνήθως κυμαίνονται $25-$199. ΚΤΚ, BMP, CMP, λιπιδικό πάνελ, και HbA1c είναι συνήθως οι φθηνότερες·; βιταμίνη D, φερριτίνη, TSH, και μελέτες σιδήρου τείνουν να αυξάνουν τον λογαριασμό. Η επείγουσα φροντίδα συχνά γίνεται η πιο ακριβή επιλογή μόλις προστεθεί μια χρέωση επίσκεψης $99-$250. Είμαι ο Thomas Klein, MD, και όταν οι ασθενείς ρωτούν για κόστος εξέτασης αίματος, τους λέω να συγκρίνουν την ακριβή λίστα εξετάσεων—όχι μόνο το διαφημιζόμενο όνομα του πακέτου—και να κρατήσουν ένα αντίγραφο για Καντέστι Τεχνητή Νοημοσύνη ή τον/την κλινικό τους. Αν οι συντομογραφίες μπερδεύονται, ο αποκωδικοποιητής CBC και CMP βοηθά.

Από τις 2 Απριλίου 2026, ένα ΚΤΚ συνήθως κοστίζει $10-$35 πληρωμή μετρητοίς, ένα BMP $8-$30, μια CMP $10-$40, μια λιπιδικό πάνελ $15-$50, και ένα HbA1c $15-$45 σε εργαστήρια άμεσης παραγγελίας στις ΗΠΑ. Τα εξωτερικά ιατρεία νοσοκομείων συχνά χρεώνουν 2 έως 6 φορές περισσότερα για τα ίδια αναλυτικά, επειδή το δείγμα περνά μέσα από μια δομή τελών εγκατάστασης (facility fee) αντί για ένα λιανικό μενού πληρωμής μετρητοίς.
A μια τακτική εξέταση αίματος το πακέτο που διαφημίζεται σε $39 ή $59 μπορεί ακόμη να εξαιρεί το τέλος λήψης αίματος. Βλέπω συχνά $5-$25 να προστίθεται για φλεβοπαρακέντηση, $3-$15 για τη διαχείριση του δείγματος και $10-$35 για χρέωση συλλογής από το ιατρείο όταν η αιμοληψία γίνεται μέσα σε κλινική και όχι σε χώρο λιανικού εργαστηρίου.
Τον περασμένο μήνα ένας ασθενής μου έδειξε δύο αποδείξεις για σχεδόν την ίδια παραγγελία: $29 online για ΚΤΚ συν CMP, και μετά $168 σε επείγοντα περιστατικά (urgent care), επειδή η επίσκεψη του κλινικού ήταν υποχρεωτική. Η εργαστηριακή επιστήμη δεν άλλαξε· άλλαξε ο χώρος.
Το «φθηνό» δεν είναι πάντα καλύτερο. Αν χρειάζεστε μόνο εξετάσεις νεφρικής λειτουργίας, μια BMP μπορεί να απαντήσει στο ερώτημα με λιγότερα από CMP; · αν έχετε ήδη κίνδυνο για διαβήτη, HbA1c συν μια λιπιδαιμική (λιπιδαιμικό) προφίλ συνήθως αγοράζει πιο χρήσιμες πληροφορίες από ένα αόριστο πακέτο ευεξίας με 20 στοιχεία.
Ποιες συχνές εξετάσεις αίματος αυξάνουν περισσότερο το κόστος των εξετάσεων αίματος
Οι εξετάσεις που αυξάνουν το κόστος των εξετάσεων αίματος με τον ταχύτερο ρυθμό είναι η βιταμίνη D, η φερριτίνη, οι εξετάσεις θυρεοειδούς, οι εξετάσεις σιδήρου, η B12, το PSA και τα ορμονικά πάνελ. Οι βασικές εξετάσεις χημείας και γενικής εξέτασης αίματος παραμένουν σχετικά φθηνές, επειδή εκτελούνται σε αναλυτές υψηλής απόδοσης· οι ανοσοδοκιμασίες κοστίζουν περισσότερο, επειδή τα φυσίγγια αντιδραστηρίων, η βαθμονόμηση και τα βήματα ποιοτικού ελέγχου είναι ακριβότερα.

ΚΤΚ συνήθως παραμένει στο $10-$35 είναι χαμηλότερο, και η GGT μπορεί να είναι αυξημένη. Οι περισσότεροι ασθενείς βρίσκουν χρήσιμο να το ακούσουν ξεκάθαρα:, BMP στο $8-$30 εύρος, και CMP στο $10-$40 εύρος. Για προληπτικό έλεγχο, οι εξετάσεις στο γυναικείο τακτικό εργαστηριακό checklist είναι συχνά η καλύτερη σχέση αξίας/τιμής, επειδή απαντούν σε συχνές ερωτήσεις χωρίς να εκτρέπονται σε τιμολόγηση εξειδικευμένων εξετάσεων.
A TSH Το επίπεδο συνήθως κοστίζει $20-$70, και πολλά εργαστήρια κάνουν άμεση παραπομπή σε ελεύθερη T4 όταν το TSH αυξηθεί πάνω από περίπου 4,5-5,0 mIU/L. 25-υδροξυβιταμίνη D κάτω από 20 ng/mL είναι ανεπαρκές στις περισσότερες οδηγίες στις ΗΠΑ, αλλά η ίδια η εξέταση συνήθως κοστίζει $45-$110, οπότε την κρατάω συνήθως για εκτίμηση κινδύνου οστών, περιορισμένη έκθεση στον ήλιο, δυσαπορρόφηση ή επίμονα συμπτώματα, αντί να την προσθέτω αυτόματα.
Φερριτίνη συχνά κοστίζει $20-$80, σίδηρος συν TIBC περίπου $25-$90, βιταμίνη Β12 περίπου $25-$80, και Ανακοίνωση δημοσίου συμφέροντος περίπου $25-$85. Αν κάνετε έλεγχο για κίνδυνο που σχετίζεται με την ηλικία, ο οδηγός εξετάσεων αίματος για άνδρες άνω των 50 είναι καλύτερο σημείο εκκίνησης από το να αγοράσετε παρορμητικά ένα ευρύ πάνελ ορμονών.
A χειροκίνητη διαφορική ή ανασκόπηση περιφερικού επιχρίσματος αίματος μπορεί να μετατρέψει ένα $15 CBC σε ένα $40-$90 λογαριασμό. Το βλέπω συχνά σε διερευνήσεις κόπωσης, όπου μια φθηνή παραγγελία μετατρέπεται αθόρυβα σε γενική εξέταση αίματος, φερριτίνη, B12, TSH, σιδηρομελέτες και βιταμίνη D· το οδηγός εργαστηριακών εξετάσεων για την κόπωση εξηγεί ποια πρόσθετα είναι πραγματικά υψηλής απόδοσης.
Οι ασθενείς συχνά υποθέτουν ότι περισσότερα φιαλίδια σημαίνουν μεγαλύτερο κόστος. Στην πραγματικότητα, μια επιπλέον ανοσοδοκιμασία μπορεί να κοστίζει περισσότερο από την ίδια την αιμοληψία, ακόμη κι αν χρησιμοποιεί μόνο μια μικρή ποσότητα ορού από το ίδιο σωληνάριο.
Πώς συγκρίνονται τα επείγοντα/urgent care, η πρωτοβάθμια φροντίδα, τα direct labs και τα κιτ στο σπίτι
Τα εργαστήρια απευθείας προς καταναλωτές είναι συνήθως το φθηνότερο μέρος για να αγοράσετε μια τυπική εξέταση αίματος, η πρωτοβάθμια φροντίδα είναι το ενδιάμεσο, τα επείγοντα είναι τα πιο ακριβά για απλό προληπτικό έλεγχο και τα κιτ στο σπίτι κοστίζουν περισσότερο για λόγους ευκολίας. Αν σας ενδιαφέρει επίσης η ταχύτητα, ο οδηγός μας για το πραγματικούς χρόνους ολοκλήρωσης στα εργαστήρια δείχνει γιατί οι αιμοληψίες την ίδια μέρα δεν σημαίνουν πάντα απαντήσεις την ίδια μέρα.

Ένα εργαστήριο άμεσης πρόσβασης είναι συχνά η πιο καθαρή συμφωνία: επιλέγετε τις εξετάσεις, πληρώνετε εκ των προτέρων και συνήθως παραλείπετε την επίσκεψη σε κλινικό ιατρό. Σε πολλές πόλεις, ένα Γενική εξέταση αίματος συν CMP καταλήγει περίπου στα $25-$60, κάτι που είναι δύσκολο να ξεπεραστεί αν ήδη ξέρετε τι χρειάζεστε.
Η πρωτοβάθμια φροντίδα μπορεί να έχει νόημα όταν η αιματολογική εξέταση συνδέεται με μια ετήσια επίσκεψη που θα πληρώνατε ούτως ή άλλως. Όμως μια μεμονωμένη επίσκεψη μετρητοί μπορεί να προσθέσει $80-$250, και ορισμένα ιατρεία στέλνουν δείγματα σε εργαστήρια συνδεδεμένα με νοσοκομεία όπου η τιμή μετρητοί για μια ΚΤΚ μπορεί να εκτοξευτεί έως $45-$120 πριν ακόμη υπάρξει οποιαδήποτε ερμηνεία.
Τα επείγοντα σπάνια είναι η συμφέρουσα επιλογή για προληπτικό έλεγχο ρουτίνας. Μόνο το κόστος της επίσκεψης συνήθως είναι $99-$250, και επιπλέον, συχνά βλέπω $20-$100 σε χρεώσεις εργαστηρίου, οπότε ένας απλός έλεγχος χοληστερόλης μπορεί να γίνει μια $150-$300 αποστολή.
Τα κιτ κατ’ οίκον συνήθως βρίσκονται στο $49-$149 εύρος για περιορισμένα πάνελ και μπορεί να προσθέτουν $7-$20 για έξοδα αποστολής ή για λογιστική επανασυλλογής. Είναι χρήσιμα για ζητήματα ιδιωτικότητας, απόστασης ή κινητικότητας, αλλά τα εξωτερικά ιατρεία νοσοκομείων παραμένουν το λιγότερο διαφανές ως προς την τιμή περιβάλλον που εξετάζω· μια πληρωμή μετρητοίς CMP από $120-$350 δεν είναι καθόλου σπάνια.
Κρυφές χρεώσεις που μπορούν να διπλασιάσουν έναν τυπικό λογαριασμό εξετάσεων αίματος
Οι χρεώσεις επίσκεψης, οι χρεώσεις λήψης δείγματος, οι χρεώσεις εγκατάστασης, οι αντανακλαστικές εξετάσεις και οι επαναληπτικές λήψεις είναι οι πέντε λόγοι για τους οποίους μια συνηθισμένη αιμοληψία μετατρέπεται σε έναν απροσδόκητα μεγάλο λογαριασμό. Οι περισσότεροι ασθενείς κοιτούν μόνο την τιμή του αυτοκόλλητου του πάνελ και χάνουν τα υπόλοιπα.

Μια χρέωση αιμοληψίας ύψους $5-$25 είναι συνηθισμένη και μια χρέωση συλλογής ή διοικητική χρέωση από την κλινική ύψους $10-$35 δεν είναι ασυνήθιστη. Εργαστήρια που συνδέονται με εγκαταστάσεις μπορεί να προσθέτουν χρεώσεις διαχείρισης που ωθούν μια σχετικά $30 παραγγελία πιο κοντά στο $60-$90 προτού ο κλινικός ιατρός την έχει καν κοιτάξει.
Τα λάθη στη νηστεία είναι μια αθόρυβη διαρροή χρημάτων. Ένα γεύμα πλούσιο σε τριγλυκερίδια μπορεί να αυξήσει το τριγλυκερίδια κατά 20%-30% για αρκετές ώρες, και ένα πρωινό με καφέ και κρέμα μπορεί να επηρεάσει αρκετά τη νηστική γλυκόζη ώστε να απαιτηθεί επαναληπτική λήψη· ο οδηγός μας για το τη νηστεία πριν από τις εξετάσεις αίματος εξηγεί ποιες εξετάσεις πραγματικά χρειάζονται την επιπλέον προετοιμασία.
Οι αντανακλαστικές εξετάσεις μπορεί να είναι έξυπνες, αλλά πρέπει να ξέρετε ότι υπάρχουν. Τις βλέπω συχνά σε πακέτα εξετάσεων πριν από χειρουργείο, όπου οι εξετάσεις PT/INR, ο έλεγχος ομάδας αίματος ή οι επαναληπτικές βιοχημικές εξετάσεις προστίθενται από προεπιλογή, ακόμη κι όταν το χειρουργικό κέντρο δεν τις απαιτεί πάντα.
HbA1c δεν απαιτεί νηστεία, γι’ αυτό είναι συχνά το πιο πρακτικό τεστ διαλογής για τον διαβήτη για πολυάσχολους ασθενείς. Ρωτήστε τέσσερα πράγματα πριν πληρώσετε: τους ακριβείς αναλύτες, ποιος χρεώνει τη λήψη, ποια αντανακλαστικά/αυτόματες παραγγελίες ενεργοποιούνται και αν μια επαναληπτική λήψη λόγω αιμόλυσης ή κακής νηστείας χρεώνεται ξανά.
Προγράμματα με προτεραιότητα στον προϋπολογισμό για μια τυπική εξέταση αίματος
Αν ο προϋπολογισμός σας είναι περιορισμένος, ξοδέψτε τον σε βαθμίδες: περίπου $25 αγοράζει ένα χρήσιμο τεστ, $50 αγοράζει ένα ισχυρό ζεύγος διαλογής, $100 αγοράζει ένα λογικό πακέτο γενικής υγείας και το $200 είναι εκεί όπου αρχίζουν να βγάζουν νόημα οι εξειδικευμένες προσθήκες. Αυτό είναι το κομμάτι που συνήθως εκτιμούν περισσότερο οι ασθενείς.

Με $25, αγοράστε ένα τεστ που απαντά σε μια πραγματική ερώτηση. Για τον καρδιαγγειακό κίνδυνο, ένα λιπιδικό πάνελ στο $15-$50 είναι συχνά η καλύτερη αγορά·; τριγλυκερίδια πάνω από 150 mg/dL είναι αυξημένα, και LDL χοληστερόλη κάτω από 100 mg/dL είναι κοντά στο άριστο για πολλούς ενήλικες.
Με $50, συχνά προτιμώ λιπιδαιμικό προφίλ συν HbA1c ή Γενική εξέταση αίματος συν CMP. Το δικό μας οδηγός ορίου HbA1c εξετάζει τους βασικούς αριθμούς: κάτω από 5.7% είναι φυσιολογική, 5.7%-6.4% υποδηλώνει προδιαβήτη, και 6,5% ή υψηλότερη υποστηρίζει τη διάγνωση του διαβήτη όταν επιβεβαιώνεται κατάλληλα.
Με $100, οι περισσότεροι ασθενείς μπορούν να χτίσουν ένα σταθερό ετήσιο τεστ διαλογής: ΚΤΚ, CMP, λιπιδικό πάνελ, και HbA1c συχνά ταιριάζει, ανάλογα με τις τοπικές τιμές. Αν τα συμπτώματα δείχνουν έντονα νόσο θυρεοειδούς ή έλλειψη σιδήρου, θα το αντικαθιστούσα με TSH ή φερριτίνη αντί να επεκτείνω τυφλά το “καλάθι”.
Με $200, οι πρόσθετες εξετάσεις γίνονται επιλεκτικές και όχι αυτόματες. Το οδηγός για το εύρος βιταμίνης D εξηγεί γιατί 25-υδροξυβιταμίνη D κάτω από 20 ng/mL είναι έλλειψη, 20-29 ng/mL συχνά αποκαλείται ανεπάρκεια, και γιατί αυτή η πιο ακριβή εξέταση πρέπει να κρατιέται για σαφείς κλινικούς λόγους.
Πότε το timing και τα λάθη στη νηστεία αυξάνουν το πραγματικό κόστος
Ο χρόνος δεν αλλάζει το δημοσιευμένο κόστος της εξέτασης αίματος, αλλά αλλάζει την πιθανότητα να πληρώσετε δύο φορές. Οι συνηθισμένες παγίδες είναι η πρόσφατη άσκηση, ο από του στόματος σίδηρος, η βιοτίνη και η λήψη της λάθος εξέτασης τη λάθος ώρα της ημέρας.

Φερριτίνη κάτω από 15 ng/mL υποδηλώνει έντονα έλλειψη σιδήρου, ωστόσο 15-30 ng/mL μπορεί ακόμη να ταιριάζει με πραγματικά συμπτώματα. Η φερριτίνη είναι αρκετά σταθερή μέσα στη διάρκεια της ημέρας και δεν απαιτεί νηστεία, ενώ ο σίδηρος ορού και ο κορεσμός τρανσφερρίνης παρουσιάζουν μεγαλύτερες διακυμάνσεις μετά τα γεύματα και τα συμπληρώματα· στο δικό μας οδηγός αναφοράς για τη φερριτίνη εξηγεί γιατί αυτές οι εξετάσεις δεν πρέπει να αντιμετωπίζονται ως εναλλάξιμες.
Κάποτε εξέτασα ένα 52χρονος δρομέας μαραθωνίου με AST 89 U/L το πρωί μετά από έναν αγώνα. Πέντε ημέρες ξεκούρασης αργότερα η τιμή ομαλοποιήθηκε και η επανάληψη τον γλίτωσε από έναν έλεγχο ηπατικής λειτουργίας που θα κόστιζε πολύ περισσότερο από το αρχικό πάνελ.
Λαμβάνοντας 65 mg στοιχειακού σιδήρου το βράδυ πριν από ένα πάνελ σιδήρου μπορεί παροδικά να αυξήσει τον σίδηρο ορού και τον κορεσμό. Στο δικό μας οδηγός σπουδών σιδήρου, εξηγούμε γιατί πολλοί κλινικοί γιατροί ζητούν από τους ασθενείς να διακόψουν τον σίδηρο για περίπου , σταματήστε την υψηλής δόσης και τη βιοτίνη υψηλής δόσης για 48-72 ώρες πριν από ανοσοπροσδιορισμούς όπως TSH.
Μικρή συμβουλή, μεγάλη εξοικονόμηση: κάντε μία σωστά χρονισμένη λήψη αντί για δύο μπερδεμένες.
Είναι όντως φθηνότερες οι εξετάσεις αίματος στο σπίτι
Τα κιτ για το σπίτι είναι συνήθως πιο βολικά από τα φθηνότερα, και λειτουργούν καλύτερα για μια περιορισμένη ομάδα εξετάσεων. Μπορούν να είναι λογικά για HbA1c, λιπίδια ή επιλεγμένες ορμόνες, αλλά αποτελούν κακή υποκατάσταση για τη φλεβική εξέταση όταν χρειάζεστε ΚΤΚ, κάλιο, ESR ή εξετάσεις πήξης.

Τα περισσότερα κιτ για το σπίτι κυμαίνονται γύρω από $49-$149 για περιορισμένο μενού αναλυτών. Ανά αναλύτη, αυτό συχνά είναι 1,3x έως 2,5x η τιμή μιας απευθείας λήψης από εργαστήριο, και το premium αγοράζει κυρίως ευκολία, ιδιωτικότητα και λογιστική αποστολής.
Τα τριχοειδή δείγματα είναι πιο εύθραυστα απ’ ό,τι περιμένουν οι ασθενείς. Η αιμόλυση μπορεί να τα κάνει κάλιο πάνω από 5,5 mmol/L ψευδώς, και τα μη επαρκώς γεμισμένα αποξηραμένα στίγματα μπορούν να καταστρέψουν ΚΤΚ παραμέτρους, επειδή οι μετρήσεις κυττάρων εξαρτώνται από διατηρημένο πλήρες αίμα και όχι από εν μέρει αποδομημένο τριχοειδικό υλικό.
Η κατ’ οίκον εξέταση έχει περισσότερο νόημα για ζητήματα κινητικότητας, πρόσβαση σε αγροτικές περιοχές, ιδιωτικότητα ή διαδοχική παρακολούθηση ενός γνωστού προβλήματος, όπως ο έλεγχος για διαβήτη. Μόλις επιστρέψει το κιτ, ο οδηγός μας για το πώς να διαβάσετε εξετάσεις αίματος σας βοηθά να ξεχωρίσετε τι είναι φυσιολογική διακύμανση και τι χρειάζεται σωστή επανεξέταση με νέα λήψη.
Αν ανεβάσετε ένα PDF ή μια φωτογραφία από το τηλέφωνο στο την ανάλυση αίματος με AI, το Kantesti μπορεί να επισημάνει αν ένα τριχοειδές αποτέλεσμα φαίνεται αρκετά αξιόπιστο για να προχωρήσετε ή αν θα το επιβεβαίωνα με φλεβικό δείγμα πριν ξοδέψετε περισσότερα χρήματα στη συνέχεια.
Πώς να συγκρίνετε προσφορές ρουτίνας από εργαστήρια πριν πληρώσετε
Ο πιο έξυπνος τρόπος για να συγκρίνετε προσφορές είναι να ζητήσετε τα ακριβή αναλυτικά, τον τύπο δείγματος, τους κανόνες reflex, τον χρόνο παράδοσης και την τελική τιμή μετρητοίς, πριν ληφθεί οποιοδήποτε αίμα. Ένα ασαφές όνομα πάνελ δεν είναι προσφορά.

Ζητήστε λίστα ανά γραμμή και όχι όνομα πακέτου. Ένα CMP περιλαμβάνει ήδη γλυκόζη, ασβέστιο, αλβουμίνη, ολική πρωτεΐνη, ALT, AST, ALP, χολερυθρίνη, νάτριο, κάλιο, χλώριο, CO2, BUN και κρεατινίνη, οπότε το να πληρώσετε επιπλέον για ξεχωριστή γλυκόζη ή μίνι-πάνελ ήπατος στην ίδια παραγγελία μπορεί να είναι διπλοκαταμέτρηση.
Ρωτήστε αν το εργαστήριο τιμολογεί TSH με reflex σε ελεύθερη T4 ή αν τιμολογεί και τα δύο από την αρχή. Η παραγγελία reflex συχνά είναι φθηνότερη, επειδή μόνο οι μη φυσιολογικές τιμές TSH ενεργοποιούν τη δεύτερη εξέταση, και η ίδια λογική ισχύει για χειροκίνητες διαφορικές μετρήσεις ή για επανεξέταση από παθολογοανατόμο όταν το βασικό ΚΤΚ είναι διαφορετικά φυσιολογικό.
Ρωτήστε ποιες τιμές αναφοράς χρησιμοποιεί το εργαστήριο και πώς επικυρώνονται τα μη φυσιολογικά αποτελέσματα. Το Kantesti AI συγκρίνει τα αποτελέσματα με κλινικά τεκμηριωμένο πλαίσιο και το δικό μας πρότυπα ιατρικής επικύρωσης δείχνει γιατί ένα ALT ανώτατο όριο 33 U/L έναντι 45 U/L μπορεί να αλλάξει την ερμηνεία και τις δαπάνες παρακολούθησης.
Πριν αγοράσετε ένα πακέτο, χρησιμοποιήστε τον οδηγό μας 15,000+ βιοδεικτών για να δείτε τι υπάρχει πραγματικά μέσα. Αν θέλετε την πλευρά της μεθοδολογίας, το οδηγός τεχνολογίας AI εξηγεί πώς η ερμηνεία βάσει προτύπων μπορεί να αποτρέψει έναν περίεργο αριθμό από το να πυροδοτήσει μια πανικόβλητη ξέφρενη αγορά.
Γιατί ένα μόνο μη φυσιολογικό αποτέλεσμα μπορεί να κάνει το κόστος των εξετάσεων αίματος να “εκτοξευθεί”
Ένα μη φυσιολογικό αποτέλεσμα μιας απλής ρουτίνας μπορεί να οδηγήσει σε 2 έως 6 εξετάσεις παρακολούθησης, και αυτή η αλυσίδα μετράει περισσότερο για το πορτοφόλι σας από την αρχική τιμή του πρώτου πίνακα. Η σωστή επιλογή του πρώτου πίνακα είναι ο τρόπος για να αποτρέψετε τη σπατάλη.

Μια ήπια αυξημένη τιμή ALT ή AST μπορεί να οδηγήσει σε επανάληψη εξετάσεων ηπατικών ενζύμων, χολερυθρίνης, ALP, GGT, ορολογικών εξετάσεων για ηπατίτιδες, φερριτίνης και μερικές φορές υπερηχογραφήματος. Ο οδηγός για τα επόμενα βήματα με ALT δείχνει γιατί το ALT πάνω από περίπου 40 U/L είναι συχνό, αλλά όχι πάντα ένδειξη ηπατικής νόσου. Έπειτα διαβάστε τις ενδείξεις από το AST αν στην ιστορία περιλαμβάνονται πρόσφατη άσκηση, στατίνες ή μυϊκός τραυματισμός.
GGT πάνω από 60 IU/L στους ενήλικες άνδρες συχνά ωθεί τους κλινικούς προς ερωτήματα για αλκοόλ, χοληφόρους πόρους ή φάρμακα, αντί για μυϊκές αιτίες. Γι’ αυτό ένα φθηνό CMP μπορεί να εξελιχθεί σε πιο εκτεταμένο έλεγχο ηπατοχοληφόρων· ο οδηγός μας για υψηλή GGT εξηγεί το μοτίβο.
Η παρακολούθηση για τους νεφρούς μπορεί επίσης να «φουσκώσει». Ένα κρεατινίνη αποτέλεσμα που αυξάνει μόνο 0.2-0.3 mg/dL μπορεί να πυροδοτήσει επανάληψη BMP, αλβουμίνη ούρων, κυστατίνη C ή νεφρική απεικόνιση, και ένα επανεξέταση του λόγου BUN/κρεατινίνης μπορεί να σας βοηθήσει να δείτε πότε η αφυδάτωση είναι η απλούστερη εξήγηση, επειδή ένας λόγος άνω του 20 συχνά δείχνει προς αυτήν την κατεύθυνση όταν τα υπόλοιπα ταιριάζουν.
Ο κανόνας μου είναι απλός: πληρώστε για το φθηνότερο πάνελ που μπορεί πραγματικά να απαντήσει στο κλινικό ερώτημα και, στη συνέχεια, ξοδέψτε τα υπόλοιπα μόνο αν η πρώτη απάντηση είναι μη φυσιολογική ή αν η διαχείριση θα άλλαζε. Η υπερβολική δαπάνη συμβαίνει κυρίως όταν οι ασθενείς αγοράζουν ευρεία πάνελ πριν καν ξέρουν ποιο πρόβλημα προσπαθούν να λύσουν.
Τι να κάνετε αφού πάρετε τα αποτελέσματα ώστε να μην πληρώσετε δύο φορές
Μόλις έχετε τα αποτελέσματα, μην ξαναζητήσετε την ίδια συνήθη εξέταση αίματος μόνο επειδή η αναφορά φαίνεται κρυπτική. Μια προσεκτική ερμηνεία συνήθως κοστίζει λιγότερο από μία επαναληπτική λήψη, ειδικά όταν το πρώτο δείγμα έχει ήδη απαντήσει στο ερώτημα.
Κρατήστε το αρχικό PDF, την ώρα συλλογής, την κατάσταση νηστείας και το όνομα του εργαστηρίου. Ένα λιπιδικό πάνελ που λαμβάνεται μετά από 14 ώρες νηστείας δεν είναι άμεσα συγκρίσιμο με ένα που λαμβάνεται μετά από 8 ώρες, και ένα TSH ενώ παίρνετε 10 mg βιοτίνης μπορεί να παραπλανήσει περισσότερο απ’ όσο ενημερώνει.
Στο Kantesti, οι γιατροί και οι επιστήμονες δεδομένων μας εξετάζουν συνεχώς αυτές τις παγίδες πλαισίου και το Ιατρική Συμβουλευτική Επιτροπή καθορίζει τα κλινικά πρότυπα πίσω από το μοντέλο. Ο Thomas Klein, MD, συνήθως λέει στους ασθενείς το ίδιο πράγμα που θα σας πω κι εγώ εδώ: μία ερμηνευμένη αναφορά υπερισχύει τριών αγχωδών επανελέγχων.
Μπορείτε να ανεβάσετε ένα PDF εργαστηρίου ή μια φωτογραφία από το τηλέφωνο στο Δοκιμάστε το δωρεάν demo μας και λάβετε μια ερμηνεία σε περίπου 60 δευτερόλεπτα, συμπεριλαμβανομένης της ανάλυσης τάσεων και του πλαισίου οικογενειακού κινδύνου. Το Kantesti AI μπορεί να αναλύσει 15,000+ βιοδεικτών, κάτι που έχει σημασία όταν μια λεγόμενη «τυπική» εξέταση αίματος περιλαμβάνει αθόρυβα περισσότερους αριθμούς από τους λίγους που προσέξατε.
Συμπέρασμα: συγκρίνετε πρώτα τις επιλογές, αγοράστε μόνο τις εξετάσεις που απαντούν στο πραγματικό σας ερώτημα και ερμηνεύστε καλά το πρώτο σύνολο πριν πληρώσετε για δεύτερο.
Ερευνητικές δημοσιεύσεις και πιο εις βάθος ερμηνεία
Αν θέλετε ερμηνεία συνδεδεμένη με έρευνα πέρα από την τιμολόγηση, ξεκινήστε από τη δουλειά της της κλινικής μας ομάδας και στη συνέχεια να επιστρέφετε κάθε μη φυσιολογικό αποτέλεσμα σε έναν αδειοδοτημένο ιατρό που γνωρίζει το ιστορικό σας. Αυτές οι δημοσιεύσεις δεν είναι τιμοκατάλογοι· είναι το είδος του βαθύτερου πλαισίου που αποτρέπει τις περιττές επαναληπτικές εξετάσεις.

Klein, T. (2026). Ουροχολινογόνο σε εξέταση ούρων: Πλήρης οδηγός γενικής εξέτασης ούρων 2026. Zenodo. https://doi.org/10.5281/zenodo.18226379. Διατίθεται επίσης μέσω Πύλη Έρευνας και Academia.edu.
Klein, T. (2026). Οδηγός για εξετάσεις σιδήρου: TIBC, κορεσμός σιδήρου και ικανότητα δέσμευσης. Zenodo. https://doi.org/10.5281/zenodo.18248745. Διατίθεται επίσης μέσω Πύλη Έρευνας και Academia.edu.
Συχνές Ερωτήσεις
Πόσο κοστίζει μια τακτική εξέταση αίματος χωρίς ασφάλιση;
Στις ΗΠΑ, μια συνήθης εξέταση αίματος χωρίς ασφάλιση συνήθως κοστίζει $8-$55 ανά μεμονωμένη εξέταση σε εργαστήριο άμεσης πρόσβασης, και τα συνήθη πακέτα συνήθως κοστίζουν $25-$199. Ένα ΚΤΚ συχνά κυμαίνεται $10-$35, μια CMP $10-$40, μια λιπιδικό πάνελ $15-$50, και ένα HbA1c $15-$45. Η επείγουσα φροντίδα είναι συχνά πιο ακριβή, επειδή μόνο το κόστος της επίσκεψης συνήθως είναι $99-$250 πριν προστεθούν οι χρεώσεις για το εργαστήριο. Ρωτήστε αν περιλαμβάνονται οι χρεώσεις φλεβοπαρακέντησης $5-$25 ή χρεώσεις διαχείρισης, επειδή αυτές οι μικρές επιπλέον χρεώσεις αλλάζουν το πραγματικό σύνολο.
Είναι το επείγον ιατρείο φθηνότερο από έναν γιατρό πρωτοβάθμιας φροντίδας για εξετάσεις αίματος;
Για προληπτικό έλεγχο ρουτίνας, η επείγουσα φροντίδα συνήθως είναι δεν φθηνότερη από την πρωτοβάθμια φροντίδα. Η επείγουσα φροντίδα συχνά προσθέτει υποχρεωτική χρέωση επίσκεψης $99-$250, οπότε ένας απλός έλεγχος χοληστερόλης ή διαβήτη μπορεί να γίνει $150-$300 επίσκεψη ακόμη και πριν από την παρακολούθηση. Η πρωτοβάθμια φροντίδα μπορεί να είναι πιο αποδοτική οικονομικά αν η αιμοληψία συνδεθεί με μια ετήσια επίσκεψη που επρόκειτο ούτως ή άλλως να προγραμματίσετε, αν και ορισμένα ιατρεία εξακολουθούν να στέλνουν δείγματα σε εργαστήρια νοσοκομείων με υψηλότερες τιμές. Συνήθως κρατάω την επείγουσα φροντίδα για συμπτώματα που χρειάζονται ιατρική κρίση την ίδια ημέρα, όχι για μια τυπική εξέταση αίματος.
Ποιες συνήθεις εξετάσεις αίματος κοστίζουν συνήθως τα περισσότερα όταν πληρώνονται απευθείας από τον ασθενή;
Οι συνήθεις εξετάσεις που αυξάνουν πιο συχνά το κόστος όταν πληρώνει ο ασθενής απευθείας είναι βιταμίνη D, TSH με προσθήκες θυρεοειδούς, φερριτίνη, μελέτες σιδήρου, βιταμίνη Β12, Ανακοίνωση δημοσίου συμφέροντος, και οι ορμονικοί πίνακες. Οι τυπικές τιμές μετρητοπληρωμής είναι περίπου $20-$70 για TSH, $20-$80 για φερριτίνη, $25-$90 για σίδηρος συν TIBC, $25-$80 για Β12, και $45-$110 για 25-υδροξυβιταμίνη D. Αυτές οι αναλύσεις κοστίζουν περισσότερο επειδή χρησιμοποιούν πιο εξειδικευμένες μεθόδους ανοσοπροσδιορισμού και βήματα ποιοτικού ελέγχου από μια βασική ΚΤΚ ή CMP. Οι ασθενείς συχνά εκπλήσσονται όταν μια μόνο εξειδικευμένη προσθήκη μπορεί να κοστίζει περισσότερο από το υπόλοιπο του πίνακα μαζί.
Μπορώ να παραγγείλω μια τυπική εξέταση αίματος χωρίς να δω γιατρό;
Σε πολλές πολιτείες των ΗΠΑ, ναι—μπορείτε να αγοράσετε ένα ΚΤΚ, CMP, λιπιδικό πάνελ, HbA1c, ή άλλες κοινές εξετάσεις απευθείας από μια εταιρεία εργαστηρίου τύπου λιανικής, χωρίς πρώτα να δείτε γιατρό. Το πλεονέκτημα μετρητοπληρωμής είναι ότι συχνά παραλείπετε μια $80-$250 επίσκεψη στο ιατρείο. Το “αλλά” είναι ότι οι κανόνες διαφέρουν ανά πολιτεία, ορισμένες εξειδικευμένες εξετάσεις περιορίζονται και τα μη φυσιολογικά αποτελέσματα εξακολουθούν να χρειάζονται κλινική παρακολούθηση. Αν το αποτέλεσμα είναι απροσδόκητο, μια φθηνή εξέταση που παραγγέλνεται απευθείας μπορεί ακόμη και να οδηγήσει σε φυσιολογική επίσκεψη στο ιατρείο ή σε συμβουλή ειδικού μετά.
Είναι οι εξετάσεις αίματος στο σπίτι φθηνότερες από το να πάτε σε εργαστήριο;
Συνήθως όχι. Τα κιτ για το σπίτι συχνά κοστίζουν $49-$149 για περιορισμένο μενού εξετάσεων, το οποίο συνήθως είναι 1,3x έως 2,5x πιο ακριβές ανά αναλύτη από το να πάτε σε εργαστήριο άμεσης πρόσβασης για φλεβική λήψη. Είναι οι καλύτερες επιλογές για ευκολία, ιδιωτικότητα ή περιορισμένη πρόσβαση—όχι για τη μέγιστη αξία. Επίσης δεν ταιριάζουν καλά για ΚΤΚ, κάλιο, ESR και εξετάσεις πήξης, επειδή τα τριχοειδή ή τα αποξηραμένα δείγματα αίματος είναι πιο ευάλωτα σε πήξη, αιμόλυση και αποτυχία συλλογής.
Χρειάζεται να νηστέψω για μια τακτική εξέταση αίματος;
Δεν χρειάζονται όλες οι συνήθεις εξετάσεις αίματος νηστεία. HbA1c απαιτεί δεν απαιτούν νηστεία, και φερριτίνη συνήθως είναι αρκετά σταθερό ώστε η νηστεία να μην είναι το βασικό ζήτημα, αλλά η νηστεία βοηθά για ορισμένα λιπιδικά πάνελ, τη γλυκόζη εξετάσεις και τμήματα μιας μελέτης σιδήρου, ανάλογα με το κλινικό ερώτημα. Το νερό γενικά είναι εντάξει, ενώ ο καφές με κρέμα ή ζάχαρη μπορεί να ακυρώσει τον σκοπό μιας λήψης για γλυκόζη νηστείας. Το ζήτημα του κόστους είναι πρακτικό: αν προετοιμαστείτε άσχημα και το αποτέλεσμα δεν ερμηνεύεται, μπορεί να πληρώσετε για δεύτερη λήψη.
Τι πρέπει να ρωτήσω πριν πληρώσω μετρητά για εξετάσεις αίματος;
Ζητήστε το ακριβείς αναλύτες, το συνολικό κόστος μετρητοίς, το χρέωση λήψης, το κανόνες αυτόματης παραπομπής, και το χρόνος ολοκλήρωσης πριν συλλεχθεί το δείγμα. Μια CMP περιλαμβάνει ήδη 14 συνηθισμένοι αναλύτες, οπότε το να πληρώνετε ξεχωριστά για διπλές εξετάσεις γλυκόζης ή ηπατικές εξετάσεις μπορεί να σπαταλήσει χρήματα. Ρωτήστε αν υπάρχουν μη φυσιολογικές TSH αυτόματες παραπομπές σε ελεύθερη T4, αν οι χειροκίνητοι διαφορικοί τύποι αιμοσφαιρίων χρεώνονται ξεχωριστά και αν μια επαναληπτική λήψη λόγω αιμόλυσης χρεώνεται ξανά. Από την εμπειρία μου, αυτές οι ερωτήσεις εξοικονομούν περισσότερα χρήματα στους ασθενείς από το να ψάχνουν για έναν κουπόνι $5.
Λάβετε σήμερα ανάλυση εξετάσεων αίματος με AI
Εγγραφείτε σε πάνω από 2 εκατομμύρια χρήστες παγκοσμίως που εμπιστεύονται το Kantesti για άμεση, ακριβή ανάλυση εργαστηριακών εξετάσεων. Ανεβάστε τα αποτελέσματα εξετάσεων αίματος και λάβετε ολοκληρωμένη ερμηνεία βιοδεικτών του 15,000+ μέσα σε δευτερόλεπτα.
📚 Παραπομπές σε δημοσιεύσεις έρευνας
Klein, T., Mitchell, S., & Weber, H. (2026). Ουροβιλινογόνο σε εξέταση ούρων: Οδηγός πλήρους γενικής εξέτασης ούρων 2026. Ιατρική έρευνα του Kantesti με AI.
Klein, T., Mitchell, S., & Weber, H. (2026). Οδηγός Μελετών Σιδήρου: TIBC, Κορεσμός Σιδήρου & Ικανότητα Σύνδεσης. Ιατρική έρευνα του Kantesti με AI.
📖 Συνεχίστε την ανάγνωση
Ανακαλύψτε περισσότερους ιατρικούς οδηγούς με αξιολόγηση από ειδικούς από την Καντέστι ιατρική ομάδα:

Εξέταση αίματος για δείκτες όγκου: Ποιες αξίζει να παραγγείλετε
Ερμηνεία εργαστηριακών δεικτών καρκίνου – ενημέρωση 2026 για ασθενείς φιλική προς τον χρήστη. Οι περισσότεροι δείκτες αιματολογικών εξετάσεων για τον καρκίνο δεν είναι κατάλληλα εργαλεία προσυμπτωματικού ελέγχου για...
Διαβάστε το άρθρο →
Χαμηλή εξέταση αίματος για τεστοστερόνη: επίπεδα, αιτίες, επόμενα βήματα
Ενημέρωση 2026 για την ερμηνεία εργαστηριακών αποτελεσμάτων στην Ενδοκρινολογία φιλική προς τον ασθενή Μόνο ένα μεμονωμένα χαμηλό αποτέλεσμα δεν αποτελεί διάγνωση. Το μοτίβο σε σχέση με το χρονικό διάστημα,...
Διαβάστε το άρθρο →
Δοκιμασία Διαφορικού Αιματολογικού: Χειροκίνητα vs Αυτόματα Αποτελέσματα
Ερμηνεία εργαστηριακών αποτελεσμάτων διαφορικής γενικής εξέτασης αίματος (CBC) – ενημέρωση 2026 για ασθενείς φιλική. Μια χειροκίνητη ανασκόπηση δεν είναι λάθος του εργαστηρίου· είναι συχνά….
Διαβάστε το άρθρο →
Βασικός μεταβολικός πίνακας CO2: χαμηλές, υψηλές και επείγουσες ενδείξεις
Ενημέρωση 2026 για την ερμηνεία εργαστηριακών τιμών BMP CO2 για ασθενείς Φιλική προς τον ασθενή Η γραμμή CO2 σε μια εξέταση αίματος BMP είναι συνήθως το….
Διαβάστε το άρθρο →
HbA1c έναντι της Σακχάρου νηστείας: Γιατί οι εξετάσεις διαφωνούν
Ερμηνεία εργαστηριακών εξετάσεων για τον διαβήτη 2026: ενημέρωση φιλική προς τον ασθενή. Μια φυσιολογική τιμή γλυκόζης νηστείας μπορεί να συνυπάρχει με υψηλό HbA1c, και...
Διαβάστε το άρθρο →
Εξέταση αίματος CRP έναντι hs-CRP: Ποιο αποτέλεσμα λάβατε;
Οδηγός CRP: Ερμηνεία Εργαστηριακών Αποτελεσμάτων 2026 – Ενημέρωση για ασθενείς με φιλικό τρόπο. Η τυπική CRP και η CRP υψηλής ευαισθησίας μετρούν την ίδια πρωτεΐνη, αλλά….
Διαβάστε το άρθρο →Ανακαλύψτε όλους τους οδηγούς υγείας μας και εργαλεία ανάλυσης αίματος με AI στο kantesti.net
⚕️ Ιατρική αποποίηση ευθύνης
Αυτό το άρθρο προορίζεται μόνο για εκπαιδευτικούς σκοπούς και δεν αποτελεί ιατρική συμβουλή. Συμβουλεύεστε πάντα έναν κατάλληλο επαγγελματία υγείας για αποφάσεις σχετικά με τη διάγνωση και τη θεραπεία.
Σήματα εμπιστοσύνης E-E-A-T
Εμπειρία
Κλινική ανασκόπηση από ιατρό για τις ροές εργασίας ερμηνείας εργαστηριακών αποτελεσμάτων.
Πραγματογνωμοσύνη
Εστίαση στην εργαστηριακή ιατρική στο πώς συμπεριφέρονται οι βιοδείκτες στο κλινικό πλαίσιο.
Αυθεντικότητα
Γραμμένο από τον Δρ. Thomas Klein με ανασκόπηση από την Δρ. Sarah Mitchell και τον Καθ. Dr. Hans Weber.
Αξιοπιστία
Ερμηνεία βασισμένη σε τεκμηριωμένα δεδομένα με σαφείς οδούς παρακολούθησης για τη μείωση του συναγερμού.
